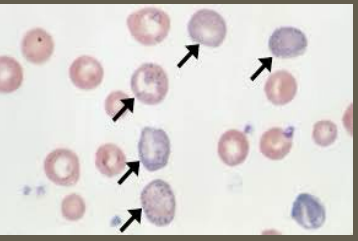
<p><strong>Lead Poisoning: Labs</strong></p><p>-CBC → _________ stippling common</p><p>-Iron studies → associated with ____ deficiency anemia </p><p>-Blood lead levels </p><ul><li><p>>_ mcg/dL leads to diagnosis</p></li><li><p>>10 mcg/dL leads to more ______ symptoms </p></li><li><p>>____ mcg/dL leads to encephalopathy </p></li></ul><p></p>

Pediatric Hematology/Oncology: Anemia, Leukemia, and Lymphoma
1/26
There's no tags or description
Looks like no tags are added yet.
Name | Mastery | Learn | Test | Matching | Spaced |
|---|
No study sessions yet.
27 Terms
hematocrit, 2, hemoglobin, thalassemia, systemic, marrow, large, B12, loss, destruction, DIC
Anemia: Background
-Quantitative Definition → any hemoglobin or __________ value that is _ standard deviations below the mean for age and gender
-Hypochromic, microcytic → inadequate production of ____________
Iron deficiency anemia, ___________, and lead intoxication
-Normochromic, normocytic → usually associated with ________ illnesses that impair _________ synthesis of RBCs
Malignancy, renal failure, inflammatory diseases
-Macrocytic → ______ RBCs
Vitamin ____ deficiency, folic acid deficiency, hypothyroidism, recent blood _____
-Hemolytic → caused by disorders intrinsic or extrinsic to the RBC that increases cell ____________
Hemoglobinopathies, G6PD deficiency, ____, HUS, TTP
jaundice, family, murmur, exercise, fatigue, purpura, growth
Anemia: History and Exam
-History → blood loss, history of _________ or pallor, dietary history, _______ history (especially anemia and chronic diseases), systemic complaints (chronic illness)
-Exam → tachycardia, systolic flow _________, poor ________ tolerance, headache, excessive sleeping or ________, irritability, syncope, jaundice or petechiae/________, ______ failure or poor weight gain
CBC, RBC, increased, decreased, bone marrow, destroyed
Anemia: Work-Up and Reticulocyte
-Initial Work-Up → ____ with diff, reticulocyte count, and blood smear
-Further Work-Up → based on initial results
Whether ____ production is adequate or inadequate and if the cells are microcytic, normocytic, or macrocytic
-Reticulocyte Counts
Elevated reticulocyte count → _________ RBC production (hemolysis or blood loss)
Normal reticulocyte count → _________ or ineffective production of RBCs for the degree of anemia
Decreased reticulocyte count → ______ ________ hasn’t had time to respond, reticulocytes are being __________ in the marrow, or bone marrow is present
milk, large, decreased, 6, 6-24, menstruating, asymptomatic, pallor, dizziness
Iron Deficiency Anemia: Background and Symptoms
-Etiology/Epidemiology
Infants < 1 y/o who are fed cow’s ______
Toddlers who are fed ______ amounts of cow’s milk leading to decreased intake of food
Menstruating adolescents
Chronic inflammatory diseases
Rarely seen in children <_ months
Most commonly seen between __-___ months or in _________ adolescents
-Symptoms
Can be ___________ if mild
______, fatigue, irritability, delayed motor development, headache, _________, and pica in moderate to severe
microcytic, anisocytosis, elevated, low, low, elevated, elemental iron, 3-5, 4-6
Iron Deficiency Anemia: Labs and Treatment
-Labs
RBCs → _______, hypochromic with ___________
MCV → low
RBC distribution width → ________
Hemoglobin → low
Absolute reticulocyte count → ____
Serum iron → low
Ferritin → ____
TIBC → _________
Transferrin saturation → low
-Treatment
_________ _____ 3-6 mg/kg/day in 3 divided doses
Reticulocyte count usually increases within __-__ days and hemoglobin follows
Anemia typically resolved within __-__ weeks
hypochromic, iron, lead, >, irritability, personality, headache, convulsions
Lead Poisoning (Plumbism): Background and Symptoms
-Associated with __________, microcytic anemia because most have ____ deficiency as well
-Etiology → _____ exposure
Living in older home (built before 1980) with lead based paint
Toxic effects likely if _ 0.5mg of lead/day absorbed
-Symptoms → weakness, ________, weight loss, vomiting, _________ changes, ataxia, constipation, ___________, abdominal pain
-Can progress to mental retardation, __________, and coma
basophilic, iron, 5, severe, 100
Lead Poisoning: Labs
-CBC → _________ stippling common
-Iron studies → associated with ____ deficiency anemia
-Blood lead levels
>_ mcg/dL leads to diagnosis
>10 mcg/dL leads to more ______ symptoms
>____ mcg/dL leads to encephalopathy
remove, Succimer, 45, symptomatic, 70, iron
Lead Poisoning: Treatment
-________ exposure
-Chelation therapy
__________ → initiated in asymptomatic children at blood lead levels > __ mcg/dL
Dimercaprol and calcium disodium EDTA → considered in ___________ children or levels > __ mcg/dL
-Correction or _____ deficiency
African, SS, anemia, deoxygenated, morphology, decreased, viscosity, hypoxia, fever
Sickle Cell Disease: Background and Pathogenesis
-Epidemiology
Most common in _______ descent
Part of the newborn screen in the US
-Sickle Cell Syndromes
Hemoglobin __ (Sickle Cell anemia, which is the most severe)
Hemoglobin S-C, hemoglobin S-Beta 0 thalassemia, hemoglobin S-Beta + thalassemia, rare variants
Sickle Cell _______ is the most common sickle cell disease
-Pathogenesis: ____________ blood/hemoglobin → Hgb crystallizes and RBC __________ distorted → _________ red cell life span (hemolytic anemia) → increased blood __________ → vaso-occlusion
Sickling exacerbated by ______, acidosis, _____, hypothermia, and dehydration
pallor, spleen, strep pneumoniae, enlargement, Hgb, shock, Parvovirus B19, dactylitis, pain, fever
Sickle Cell Disease: Symptoms
-Hemolytic Anemia → ______, fatigue, jaundice
-Splenomegaly
Congestion of _____ → splenic dysfunction/infarction → susceptible to infection (____ __________)
-Splenic sequestration crisis (life threatening)
Sudden ____________ of the spleen with pooling of red cells → drop in ____ → exacerbates anemia → can lead to ______ and death
-Aplastic crisis
Viral infection (_________ ____) of RBC precursors in marrow → transient RBC aplasia with reticulocytopenia → exacerbated anemia
-Vaso-Occlusion and Tissue Ischemia
_______ aka hand and foot syndrome (often 1st presentation)
Bone/extremity ____
Abdominal pain
Acute chest syndrome (_____, pleuritic chest pain, pulmonary infiltrates)
Stroke
electrophoresis, PCN, cultures, hydration, analgesia, anemia, failure, hydroxyurea
Sickle Cell Disease: Diagnosis and Treatment
-Diagnosis → Hemoglobin __________ to identify the type of hemoglobin
-Treatment
Prophylactic ___ (especially in HbSS and HbS-beta 0 thalassemia)
Immunizations
If febrile, order bacterial _______, close observation, broad spectrum antibiotics
Vaso-occlusive episodes → __________, correction of acidosis, ________, maintenance of oxygen saturation, and treatment of any infection
Red cell transfusion → exacerbation of ______, stroke, acute chest syndrome, organ _________
___________ → decreases hemolysis and reduces painful events by increasing fetal hemoglobin. Start if > 9 months old
ALL
What is the most common childhood cancer overall?
>, Down Syndrome, B, 2-5, older, >, immature, lymphoblasts, marrow
Acute Lymphoblastic Leukemia (ALL): Background
-Most common childhood cancer overall
-Etiology → mostly unknown; thought to have genetic and environmental factors
-Epidemiology
Caucasian _ AA
Increased incidence in individuals with ______ _________
B-precursor cell ALL is most common → peaks between __-__ years old and most cases before the age of 15. Slightly more common in males
T-cell ALL → ______ age of onset (adolescents), male _ female
-Pathogenesis: composed of ________ B or T cells called __________ → replace normal _______ → disrupts normal function
->25% of malignant blasts on a bone marrow aspirate
fevers, pallor, pain, petechiae, splenomegaly, tachypnea, palsies
ALL: Symptoms and Physical Exam
-Symptoms
Intermittent ______ → cytokine induced by the leukemia or due to secondary infections from leukopenia
Bruising
________
Bone ______ (pelvis, vertebral bodies, legs)
-Physical Exam
Can be normal
Pallor, _________, purpura, hepatomegaly/___________, lymphadenopathy
Mediastinal adenopathy → may cause SVC syndrome
Mediastinal mass → __________ and orthopnea
Leukemic infiltration of cranial nerves → cranial nerve _________
decrease, neutropenia, low, >, blasts, teardrop, infiltration, blasts, small, no
ALL: Diagnosis
-CBC with differential
_________ in at least one cell type but often more (_________, thrombocytopenia, anemia)
50% have ____ or normal WBC count with neutropenia
30% have WBC count between 10,000-50,000
20% have WBC count _ 50,000
-Peripheral Blood Smear → ______ among normal lymphocytes, ________ RBCs
-Bone marrow aspiration
Homogenous __________ of leukemic ______ replacing normal marrow
Blasts → ______, scant cytoplasm, __ nucleoli or one indistinct nucleolus
-Immunophenotyping by flow cytometry
-Histochemical stains
widening, xray
ALL: Imaging
-CXR → mediastinal __________ or anterior mediastinal mass
-Abdominal US → intra-abdominal adenopathy
-_____ of long bones and spine → demineralization, periosteal elevation, growth arrest lines, compression of vertebral bodies
2-3, remission, intrathecal, CNS, methotrexate
ALL: Treatment
-Lasts between __-__ years
-Induction Phase
>95% of patients will enter __________ in this phase
Oral prednisone/dexamethasone, IV vincristine/danurubicin, IM or IV asparaginase and intrathecal methotrexate
-Consolidation Phase
_________ chemo and continued systemic therapy. This is important because systemic chemo can’t penetrate ____ or testes very well
Possibly cranial radiation
-Intensification Phase
Intensive chemo for several months
-Maintenance Phase
Daily oral mercaptopurine, weekly oral __________, and monthly vincristine and oral steroids, and intrathecal chemo every 2-3 months
fever, cultures, bactrim, varicella, 72, acyclovir
ALL: Treatment
-Monitor for drug toxicities and complications such as infection
_____ in these patients need worked up (blood cultures, treated with broad spectrum antibiotics)
-Prophylaxis against pneumocystis jiroveci (______)
-Those who are not immune to ________ must get VZIG within __ hours of exposure and treatment with IV ________ for active infection
neonatal, adolescence, >, oncogenic, blasts, failure
Acute Myeloid Leukemia (AML): Background
-Accounts for 20% of leukemia cases
-Epidemiology
Incidence is higher in the ________ period then drops and stabilizes until _________ where there is a slight increase that continues into adulthood
Males = females
Hispanic and AA _ Caucasian
-Pathogenesis
Acquired _________ mutation → impairs differentiation → accumulation of immature myeloid ______ in the marrow and other organs → marrow ________ and complications (anemia, thrombocytopenia, neutropenia)
pallor, hematuria, purpura, stasis, lungs, 7, platelets, >
AML: Symptoms and Labs
-Symptoms
_______, fatigue, easy bleeding (epistaxis, bleeding gums, __________), ecchymosis, ________, petechiae, fevers, frequent infections
Venous _____/sludging in vessels that leads to hypoxia, hemorrhage, infarction (most often in ______ and CNS)
-Diagnosis
CBC with differential
Hgb around _
_________ < 50,000
WBCs _ 100,000
Neutrophils < 1000
aggressive, stem cell, pneumocystis, acyclovir
AML: Treatment
-Need more ________ chemotherapy because it is less responsive
-_____ ____ transplant following remission if matched donor or continued chemotherapy in those who don’t
Recommended in all patients
-Monitor, evaluate, and treat possible infections promptly
-__________ prophylaxis with bactrim
-VZIG within 72 hours of exposure to varicella or IV ________ for active infection
children, extranodal, unpredictable, Burkitt, EBV, neoplasm, 5, >
Non-Hodgkin Lymphoma: Background
-More common that Hodgkin Lymphoma in _________
-Diffuse and highly malignant
-Arises at ________ sites and spread in an ___________ manner
-Types
Mature B-cell NHL/_______ lymphoma are most common
Lymphoblastic lymphoma
Large cell lymphoma
-Risk Factors → ___ infection, congenital and acquired immunodeficiency, and previous __________
-Epidemiology → increases with age (uncommon before _ years old)
Males _ females
translocations, oncogene, pain, mass, LAD, sweats
Non-Hodgkin Lymphoma: Patho and Symptoms
-Pathogenesis → Chromosomal ____________ result in unregulated or increased expression of an _________ that drives malignant transformation
-Symptoms
Abdominal _____, vomiting, abdominal _____ (possible), cough, SOB, ___ (neck, underarm, stomach, groin), fever, night _______, weight loss
LDH, CT, biopsy, PET, chemotherapy
Non-Hodgkin Lymphoma: Diagnosis and Treatment
-Diagnosis
CBC, LFTs, serum electrolytes, ___, uric acid, CXR and ___
_______ of involved lymph node is diagnostic
Bone marrow evaluation and ____ scan for staging
-Treatment → systemic ______________
single, contiguously, sclerosis, EBV, adolescent, young
Hodgkin Lymphoma: Background
-Arises in a ______ chain of lymph nodes and spreads ___________
-Common Types
Nodular ________ (adolescents/young adults)
Mixed cellularity and nodular lymphocyte predominant (younger children)
-Risk Factors
___ infection, immunodeficiency, autoimmune lymphoproliferative syndrome
-Epidemiology
Peaks in __________/young adults and again after 50
Males > females in ______ children
Male = female in adolescent/young adult
painless, LAD, contiguous, cervical, cough, loss
Hodgkin Lymphoma: Symptoms
-_________, firm ____ confined to 1-2 ___________ lymph node areas (supraclavicular and ________ nodes most affected)
-_______ and/or shortness of breath
-Fever
-Night sweats
-Unintentional weight _____
ESR, biopsy, Reed-Sternberg, chemotherapy, surgery
Hodgkin Lymphoma: Diagnosis and Treatment
-Diagnosis
CBC, ____, electrolytes, uric acid, LDH, CXR
_______ of involved lymph node is diagnostic. Will see characteristic _____-__________ cells
PET scan for staging
-Treatment
4-6 courses of ___________
Radiation if needed
Stage I: _______ alone may cure